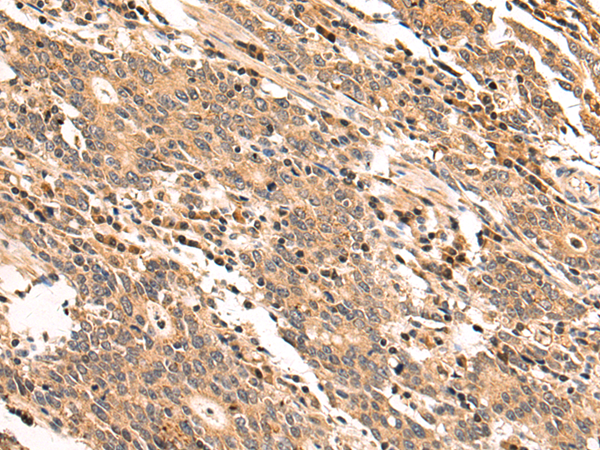

-
分类: 科研抗体货号: P09749别名: SP192应用: IHC反应种属: Human, Mouse, Rat
-
分类: 科研抗体货号: P09760别名: PRP9; PRPF9; SAP61; SF3a60应用: WB,IHC反应种属: Human, Mouse
-
分类: 科研抗体货号: P09766别名: IR10; WDR2; CLIPINB应用: IHC反应种属: Human
-
分类: 科研抗体货号: P09748别名: LPSB; SP56; hSBP; SBP56; HEL-S-134P应用: WB,IHC反应种属: Human, Mouse, Rat
-
分类: 科研抗体货号: P09758别名: SMM1; DUS2L; URLC8应用: WB,IHC反应种属: Human, Mouse
-
分类: 科研抗体货号: P09775别名:应用: WB,IHC反应种属: Human, Mouse
-
分类: 科研抗体货号: P09764别名: APP3; ICP55; NPHPL1应用: WB,IHC反应种属: Human, Mouse, Rat
-
分类: 科研抗体货号: P09757别名: IKEPP; PDZK2; NHERF4应用: IHC反应种属: Human
-
分类: 科研抗体货号: P09774别名: RFG; ELE1; PTC3; ARA70应用: IHC反应种属: Human
-
分类: 科研抗体货号: P09763别名:应用: WB,IHC反应种属: Human, Mouse

鄂公网安备42018502007531号
鄂公网安备42018502007531号

